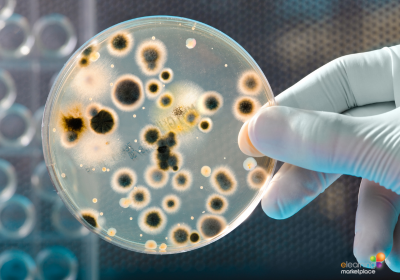

The fast-paced food industry demands absolute safety and compliance standards. HACCP (Hazard Analysis Critical Control Point) represents a systematic method that stops food safety risks from developing in the first place. The main objective of HACCP is to guarantee food products are safe for human consumption while protecting public health and building consumer trust. Therefore, it is essential to have professionals who understand HACCP. This comprehensive guide provides industry professionals with practical HACCP online training information along with relevant resources. The acquisition of HACCP principles is essential for both protecting public health and career development, regardless of your experience level. This article delves into food safety fundamentals to provide you with essential knowledge and abilities that will help you succeed in this critical field. Your organisation will achieve higher food safety standards through effective online training solutions that will transform your safety approach.
Understanding HACCP: What It Is and Why It Matters
The systematic preventive method known as HACCP (Hazard Analysis Critical Control Point) focuses on physical, chemical and biological hazards through prevention rather than finished product inspection. This method identifies food safety hazards throughout the production process and establishes control measures to reduce these risks. NASA and Pillsbury Company collaborated during the 1960s to create HACCP as a food safety system for astronauts. The HACCP system has evolved since its inception and now serves as the worldwide standard for food industry safety management systems. The principles of HACCP have become essential components of regulatory frameworks which make it mandatory for all food production and processing and distribution organisations. Food industry professionals need to understand HACCP because it offers a methodical system to detect and manage potential hazards.

Businesses that follow HACCP principles can stop contamination while decreasing foodborne illness risks and fulfilling regulatory standards. A well-established HACCP system leads to better product quality while building consumer trust and promoting ongoing organisational improvement.
The Importance of Food Safety in the Industry
Food safety is a vital matter for the food industry because it directly affects both public health and consumer trust. The presence of contaminants in food products results in dangerous health problems, which cause millions of worldwide cases of foodborne illnesses annually. The costs from medical expenses, lost work time, product recall and legal fees create substantial economic damage. Businesses, together with consumers, require high food safety standards for protection. Food safety regulations exist as legal requirements in numerous countries. The U.S. Food and Drug Administration (FDA), together with the European Food Safety Authority (EFSA) and multiple national agencies, enforces strict food safety rules that businesses must follow. Businesses that fail to meet these standards face severe consequences, which include fines, product seizures and potential business closure. A strong food safety management system represents both a legal requirement and a moral duty for businesses. Food safety requirements surpass basic compliance and risk control measures. Consumers today show growing interest in food safety and quality, which makes them more knowledgeable about their food choices in the competitive market. Food safety priority enables businesses to stand out from competitors, while building customer loyalty and improving their corporate image. Companies that invest in food safety show their dedication to consumer protection, which leads to better customer trust and sustainable business growth.
Key Principles of HACCP
The seven core principles of HACCP serve as guidelines to detect and evaluate food safety risks and implement control measures. The principles offer a structured method to maintain food safety across all stages of production. Any food industry professional who wants to learn HACCP must understand and apply these fundamental principles.
1. The first principle is conducting a hazard analysis. The process of identifying potential food safety risks occurs throughout the entire production sequence, from raw material acquisition to distribution of the finished product.
Food safety hazards exist in three forms: biological (bacteria, viruses), chemical (allergens, pesticides) and physical (metal fragments). The identified hazards receive evaluation for their probability and impact level to establish the necessary control measures.
2. The second principle is determining critical control points (CCPs). The production process contains particular points known as CCPs, which allow control measures to stop or minimize hazards until they reach acceptable levels. The identification of CCPs remains essential because it enables organisations to implement specific interventions that effectively handle food safety risks. The monitoring and control of each CCP must continue to prevent hazards from affecting product safety.
3. The third principle is establishing critical limits. Each CCP requires specific criteria known as critical limits to guarantee adequate hazard control. The established limits stem from scientific evidence and regulatory requirements and encompass measurable factors, including temperature and time, pH and other parameters. The establishment of precise critical limits guarantees that control measures function properly while maintaining food products safe for human consumption.

4. The fourth principle is to establish monitoring procedures for CCPs. Monitoring requires periodic checks and data recording to verify that each CCP remains under control. The monitoring process enables food safety teams to identify any critical limit deviations in a timely manner. The monitoring process includes visual inspections together with temperature checks and other appropriate measurements to confirm system functionality.
5. The fifth principle is to establish corrective actions. Monitoring results that show a CCP is not under control require immediate corrective actions to stop unsafe food from reaching consumers. The corrective actions include process adjustments and product rework and batch disposal. A well-defined plan for corrective actions enables immediate response to any issues, which helps maintain food safety.
6. The sixth principle is to establish verification procedures. Verification involves activities that confirm the HACCP system is working effectively. This can include reviewing monitoring records, conducting internal audits, and testing end products. Verification ensures that the HACCP system is being implemented correctly and achieving the desired food safety outcomes.
7. The seventh and final principle is to establish record-keeping and documentation procedures. The HACCP principles require accurate and complete documentation to prove compliance. The documentation system should contain hazard analysis records together with CCP determinations, critical limits, monitoring activities, corrective actions and verification results. The proper documentation system verifies the HACCP system’s operational effectiveness while serving as a foundation for ongoing improvement efforts.
Benefits of HACCP Online Training for Professionals
The food industry professionals can obtain HACCP online training to learn how to establish and maintain an effective food safety management system. The main advantage of online training is its adaptability. The training materials of online courses enable students to learn at their own speed, at any time and in any location with an internet connection. The main advantage of HACCP online training is its ability to provide high-quality and current content to learners.
The creation of online courses involves industry experts who integrate current research along with best practices and regulatory requirements. The training delivers precise information that learners can use immediately in their professional work.

The learning experience becomes more engaging through interactive elements and the opportunity to revisit any aspect of the training, as many times as required, helps with retention of information and therefore improves achievement rates. The training methods available through the internet provide budget-friendly solutions for both individual learners and organisational groups. The costs of traditional classroom training include travel expenses together with accommodation fees and course tuition fees. The elimination of training expenses through online learning makes this method more budget-friendly. After finishing their online courses, students receive certification, which serves as proof of their expertise. The certification process leads to better career opportunities because it enables professionals to move up the career ladder and earn higher salaries in their industry.
How to Choose the Right HACCP Online Training Course
Selecting the appropriate HACCP online training course is essential to achieve the best results from the training program while fulfilling your particular requirements. The first essential factor is to ensure that you undertake the correct level of HACCP training. The level of training required will depend on the specific job and level of responsibility. The levels of HACCP training are Level 1 to Level 4:
- Level 1 (Awareness):
Level 1 is an introductory level designed for all food handlers, providing a basic understanding of food safety and the principles of HACCP. This level is generally for food handlers who are not directly involved in high-risk food preparation but still handle food in some capacity, e.g. waiters, bar staff and kitchen porters.
Level 1 HACCP Online Training Courses - Level 2 HACCP (Understanding):
Level 2 builds on Level 1, providing a more in-depth understanding of HACCP principles and their application in a food business. This level is suitable for a wide range of job roles in the food industry, including those who handle, prepare, or serve food, e.g., chefs, kitchen staff, catering managers, food handlers in cafes and restaurants, hospitality staff, and mobile catering operators.
Level 2 HACCP Online Training Courses - Level 3 HACCP (Advanced):
Level 3 builds on Level 2, providing an in-depth understanding of applying HACCP principles and developing and implementing HACCP systems and plans. This level is suitable for those in supervisory and management roles in the food industry, particularly those who develop, implement, maintain and monitor HACCP systems e.g., food safety supervisors, managers and food business owners.
Level 3 HACCP Online Training Courses - Level 4 HACCP (Advanced for larger food businesses)
Level 4 builds on Level 3, providing an advanced understanding of designing, developing, implementing and evaluating Codex-based HACCP food safety management systems. Codex-based HACCP focuses on identifying, assessing, and controlling potential hazards throughout the food production process, from raw materials to consumption, to ensure food is safe. Level 4 HACCP is for larger food businesses or individuals in senior food industry roles or who are dealing with complex food handling processes e.g., senior managers, consultants, inspectors and technical managers.
Level 4 HACCP Online Training Course
The second most important factor in choosing the right online course is its content. The training should include complete coverage of the seven principles, along with food safety regulations, risk assessment and practical implementation strategies. A complete curriculum establishes fundamental knowledge that enables you to apply HACCP principles successfully in your professional work.

Choose an online course that is accredited by an Ofqual-regulated Awarding Body or recognised industry body, which means that the content has been validated to meet industry standards by an external quality assurance organisation. For example, Level 4 Award in HACCP Online Course, accredited by OCNCredit4Learning.
Next is the selection of a training provider, which should depend heavily on their reputation and credibility. Research providers’ reviews and testimonials. If your chosen provider offers accredited certification, it also means that the training provider is externally moderated by the regulated body, which reinforces the quality of the overall learning experience. The quality and effectiveness of the course should also be verified by reading reviews and testimonials from previous learners. The course format, together with its delivery method, should be considered as an essential factor. The delivery of online training programmes varies between self-paced learning and combinations of online sessions with instructor support. Choose the learning method that matches your individual learning approach, your available time and organisational requirements. The course needs to include assessment tools and knowledge checks throughout the course to check your understanding and provide feedback. The combination of structured learning methods in a well-designed course will improve your understanding of HACCP principles.
Common Challenges in Implementing HACCP
Organisations face difficulties when implementing HACCP, especially when they lack experience with this concept or have insufficient resources. The identification and evaluation of hazards presents a major obstacle to organisations. A complete hazard analysis demands extensive knowledge about production operations and potential safety threats. The process demands team effort between suppliers and production staff and quality control teams. The identification and proper assessment of all relevant hazards requires extensive time and resources.
The consistent monitoring of critical control points (CCPs) presents another implementation challenge. The verification of control measures effectiveness and food safety standards compliance depends on monitoring CCPs.
The implementation of consistent monitoring procedures becomes challenging for big or complicated operations. The solution to this challenge requires proper staff training, together with protocol development and the implementation of dependable monitoring systems.

HACCP implementation faces two major difficulties related to documentation and record-keeping. The documentation process needs to be both accurate and comprehensive because it serves as evidence for regulatory compliance and helps identify patterns that need attention. Small businesses with insufficient administrative support find it challenging to maintain detailed records. Digital record-keeping systems, together with regular documentation updates and reviews, help organisations maintain accurate and accessible records.
Real-World Applications of HACCP in Various Industries
The food industry implements HACCP across its multiple sectors through distinct applications that address unique challenges.

The meat and poultry industry depends on HACCP to regulate bacterial contamination, along with chemical residues and physical contaminants. Meat processors apply HACCP principles to guarantee product safety throughout the entire production process from slaughter to packaging and distribution. The meat industry requires strict HACCP implementation, which focuses on monitoring essential control points during storage and cooking operations.
The seafood industry depends on HACCP to handle food safety risks. Seafood products face high vulnerability to biological threats, including pathogens and parasites, and chemical threats including histamines and toxins. The seafood industry implements HACCP plans to control hazards through freezing and cooking procedures and proper handling methods. The seafood industry achieved reduced foodborne illness rates through implementing HACCP standards.
The dairy industry employs HACCP to control microbiological contaminants and chemical residues and allergens in their products. Dairy processors use HACCP principles to maintain product safety and quality throughout their production of milk cheese and yogurt. The system tracks essential control points which include pasteurisation temperature checks and sanitation procedures and storage environment monitoring. The dairy industry achieved better product safety and consumer trust through implementing HACCP standards.
Staying Compliant: HACCP Certification and Regulations
HACCP certification serves as an essential milestone for businesses that want to prove their dedication to food safety and regulatory compliance.
The certification process requires a complete assessment of both the HACCP plan and its execution by an accredited third-party certifying body. It also requires evaluation of documentation alongside on-site inspections and staff interviews. HACCP certification grants official validation of an organisation’s food safety management system, which leads to a better market position and enhanced reputation.

The HACCP regulatory framework is a legal requirement in the European Union, the United States, the United Kingdom, and Australia. Many other countries also mandate HACCP or have HACCP-based systems, sometimes with specific requirements for certain sectors like meat and poultry or for imports. Businesses must create HACCP plans under these regulations, which both identify potential risks and guarantee product safety. They must follow these regulations by law while facing periodic inspections and audits to check their compliance. The implementation of HACCP regulations exists across different nations because the global community acknowledges its essential role in food safety management. Businesses operating in the food industry must stay updated about regulatory changes while maintaining HACCP requirements for successful operations.
Conclusion: Elevating Food Safety Standards Through HACCP Online Training
The online acquisition of HACCP principles stands as a fundamental requirement for food industry professionals who want to boost their food safety management systems and safeguard public health. The HACCP system enables structured hazard detection and control, which guarantees food products reach safe consumption levels. Online training provides an adaptable method to obtain HACCP system implementation and maintenance capabilities at a reasonable cost. The selection of an appropriate HACCP online training course enables professionals to obtain complete and current information that directly applies to their work activities and contributes to their organisation’s HACCP compliance.

Food industry businesses must maintain HACCP certification and regulatory compliance to operate successfully. The achievement of HACCP certification serves as official proof of an organisation’s food safety dedication, which leads to better market position and increased customer appeal.
The success of HACCP implementation depends on resolving typical challenges, which include hazard analysis and monitoring and documentation procedures to preserve food safety standards. The real-world implementation of HACCP across different industries proves its capability to control food safety risks and enhance product quality. The implementation of HACCP training represents a preventive strategy that raises food safety levels while safeguarding consumers and developing an organisation-wide culture of ongoing improvement.
Other titles in our Ultimate Guide Series:
Ultimate Guide: Food Safety Compliance and Training
Ultimate Guide: Health and Safety Online Training for a Safer Workplace
Author: Carolyn Lewis, in consultation with HACCP experts
27th August 2025
Sources:
https://myhaccp.food.gov.uk/help/guidance/introduction-haccp-principles
https://www.gov.uk/food-safety-hazard-analysis
https://www.fda.gov/food/hazard-analysis-critical-control-point-haccp/haccp-principles-application-guidelines







 UK: 0844 854 9218 | International: +44 (0)1488 580017
UK: 0844 854 9218 | International: +44 (0)1488 580017







